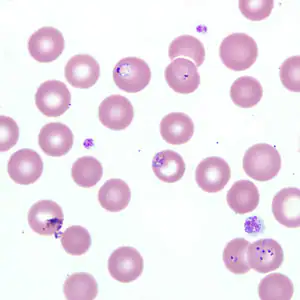
Case218_C.jpg

Case #218 – December, 2007
A 52-year-old man was seen at a hospital for fever and chills. He reported travel to wooded areas in the Northeastern United States and noted previous tick bites. For the last case study of the year, you do not have to make a diagnosis since Babesia sp. was identified on a Giemsa-stained blood smear by the hospital laboratory staff. However, the attending physician would like a parasitemia value to determine how best to manage the care and treatment of the patient. Using the images provided, please calculate the parasitemia. Happy holidays!

Figure A

Figure B
Figure C
Images presented in the DPDx case studies are from specimens submitted for diagnosis or archiving. On rare occasions, clinical histories given may be partly fictitious.
DPDx is an educational resource designed for health professionals and laboratory scientists. For an overview including prevention, control, and treatment visit www.cdc.gov/parasites/.
